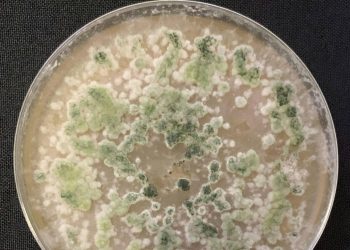

La informática encuentra un aliado en los hongos
Ordenadores confeccionados con partes sacadas de hongos, que aprovechan sus redes miceliales como arquitecturas computacionales. Suena a ciencia ficción, pero es una línea de investigación real que en los últimos años está dando resultados prometedores. «La computación biológica no es un imposible. Lleva décadas en desarrollo. En los años 90…
10/03/2026